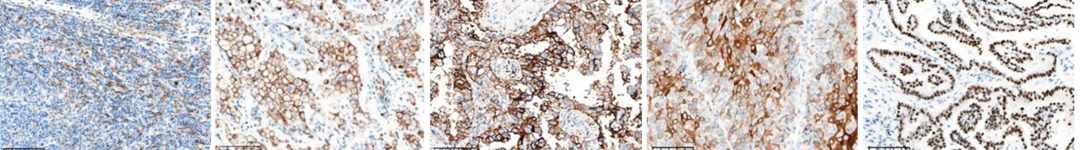

近日,熙宁生物|精翰生物参加中国非公立医疗机构协会病理学专业委员会、国家病理质控中心(PQCC)非公组联合组织的免疫组化8项和特殊染色3项室间质评活动,8项检测指标包括MLH1、MSH2、MSH6、PMS2、Claudin18.2、C-met、Her-2、Ki67,特殊染色3项检测指标包括粘液染色,抗酸染色,弹力纤维染色,11项检测指标熙宁生物|精翰生物免疫组化实验室均高分通过,荣获合格证书。


熙宁生物|精翰生物再一次高分通过病理室间质评,意味着PQCC对我们免疫组织化学全流程标准化操作与质量控制给予的充分认可,再次证明了我们规范化、标准化的实验室质量管理体系,为技术可靠、质量稳定、结果精准的优势提供了强有力证明。未来,熙宁生物|精翰生物依然会坚持高质量、高标准,为合作伙伴提供技术过硬,质量可靠,响应迅速的技术服务。
熙宁生物|精翰生物组织病理实验室秉承“合规,精准,伴随诊断”的核心理念,拥有BenchMark Ultra,Dako Autostainer Link 48,Leica Bond III等国际公认的全自动免疫组化染色平台,遵从CAP和GCP体系要求,成功完成包括PD-L1、Claudin18.2、TROP-2、HER-2、HER-3、Nectin-4、dMMR、TIM-3、MSLN、B7H3等近200种靶标的免疫组化方法开发,且多种方法已获得NordiQC、CAP、CCPI、PQCC等国内外权威机构的认可。
除上述提到的免疫组化检测,熙宁生物|精翰生物免疫组化实验室还可提供H&E染色,mIHC,FISH等技术服务,满足药企临床试验的各种病理检测需求。
对于客户的伴随诊断需求,我们已筛选出了多株具有伴随诊断开发价值的单克隆抗体并完成了前期的试剂盒开发,可随时为广大药企客户提供伴随诊断试剂盒开发服务,欢迎致电咨询。
部分IHC结果展示
GPC3
MAGE-A4
DLL3
CD276
NY-ESO-1

肝癌
黑色素瘤
脑胶质瘤
食管癌
胃癌
MSLN
PRAME
PD-1
CEACAM5
CD70

扁桃体
卵巢癌
扁桃体
结直肠
肾细胞癌
CD39
CD73
Nectin-2
Nectin-4
TGF-beta

肠癌
扁桃体
睾丸
乳腺癌
肺癌
CK5
CK7
PVR
OX40
EpCAM

扁桃体
乳腺癌
胎盘
结肠癌
肾脏
CD33
TIM-3
CD47
URO II
TTF-1
淋巴瘤
肺癌
肺癌
膀胱癌
肺癌
K16
p53
PSMA
Ki-67
CD10

皮肤
结直肠癌
前列腺癌
扁桃体
扁桃体
c-MET
AR
CCNE1
HIF-1a
p-SMAD2

肺癌
乳腺癌
卵巢癌
乳腺癌
肠癌
ATM
γ-H2A.X
STING
EZH2
pRb

卵巢癌
乳腺癌
卵巢癌
淋巴瘤
肠癌
CD3
CD4
CD8
CD4(棕色)/CD8(红色)
CD7

扁桃体
扁桃体
扁桃体
扁桃体
扁桃体
CK31
CD45
PD-1
TIGIT
LAG-3

扁桃体
扁桃体
扁桃体
扁桃体
扁桃体
专注医药研发,造福全球病患
作为一家以分析科学为核心能力,为新药临床与临床前研究提供专业技术服务的创新型CRO,熙宁生物|精翰生物在“专注医药研发,造福全球病患” 的愿景驱动下,持续投入,高速成长,致力于成为新药企业最值得信赖的伙伴。
我们竭诚为客户提供横跨临床前与临床研究的一站式检测分析服务,时刻以“技术过硬、质量可靠、响应迅速” 作为自己的服务承诺,秉持着“成就客户,求实创新,开放进取,激情敬业,坦诚直接,团队合作“的核心价值观,愿与我们的客户一道探索新药研发的无限可能。